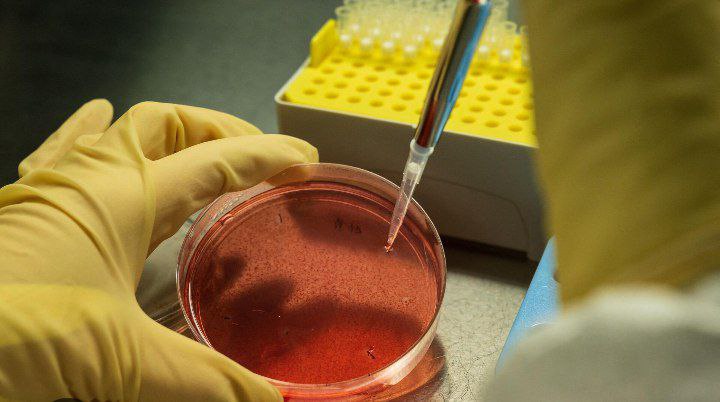

#infografika «Oʻtkir yuqumli ichak kasalliklari avj olmasligi uchun mutaxassis tavsiyasi» Sanepidqoʻmita Qarshi tuman boʻlimi Axborot xizmati https://t.me/sanepidqom_qarshitum

☑️Organizmda magniy tanqisligining belgilari ☑️Stress; ☑️Tungi tutqanoqlar; ☑️Uyquchanlik yoki uyqusizlik; ☑️Yurakning tez-tez urishi; ☑️Ortiqcha vazn; ☑️Yuzning oqarib ketishi. https://t.me/sanepidqom_qarshitum

🔶Gepatit E kasalligida xavf 🔶Agar gepatit Eni o‘z vaqtida davolashni boshlamasa, jiddiy asoratlar rivojlanishi mumkin: 🔶Jigar sirrozi. 🔶Buyrak-jigar yetishmovchiligi. 🔶Qon ivishining pasayishi. 🔶Ichki a’zolardan qon ketishi. 🔶Miya faoliyatining buzilishi. 🔶Jigar o’simtasi. 🔶O‘lim ehtimoli yuqori. https://t.me/sanepidqom_qarshitum

📌OITS (orttirilgan immunitet tanqisligi sindromi) OIV deb nomlangan virus (odam immunotanqislik virusi) sabab bo’lgan sindrom, xalq orasida ko’proq SPID kasalligi nomi bilan tanilgan. 📌Kasallik immunitet tizimini o’zgartirib, odamlarni infeksiyalar va kasalliklarga ko’proq moyil qilib qo’yadi. Bu sezuvchanlik sindrom rivojlanishi bilan yomonlashadi. 📌OIV organizmning…
✅Vabo kasalligi diagnostikasi ✅Vabo tashxisi infeksionist vrach tomonidan qo‘yiladi. Buning uchun quyidagi tahlillar va tadqiqotlar tayinlanadi: ✅qusish massalari, axlat massalari va ichak suyuqligini bakteriologik ekish; ✅serologik tadqiqotlar; ✅vibrionlarning mikroagglyutinatsiyasi va immobilizatsiyasi. ✅Vabo kasalligini boshqa ichak infeksiyalaridan (masalan, salmonellyoz va dizenteriya)…

✍🏻Gepatit E jigarning fekal-oral yo‘l bilan yuqadigan va epidemik qo‘zg‘alishlarga moyil bo‘lgan virusli kasalligi.U, odatda, yengil shaklda o‘tadi. Dunyoda har yili 20 millionga yaqin odam gepatit E bilan kasallanadi.y ✍🏻Sabablari ✍🏻Kasallik fekal-oral yo‘l bilan gepatit E virusi yuqishi natijasida yuzaga keladi.…

✅Gepatit D kasalligini davolash ✅Gepatit D ni davolash(o’tkir shakl bo’lsa) kasalxonada amalga oshiriladi. Gepatit D uchun zarur bo’lgan davolanish quyidagilarni o’z ichiga oladi: ✅virusga qarshi preparatlar; ✅gepatoprotektorlar; ✅immunomodulyatsion vositalar. ✅Gepatit D kasalligini oldini olish ✅Gepatit D kasalligi uchun profilaktika quyidagilarni…

📌Gepatit C 📌Gepatit C – bu jigarda yallig’lanishni keltirib chiqaradigan virusli infeksiya. Ba’zida jigarga jiddiy zarar yetkazishi mumkin. Virus (HCV yoki gepatit C virusi) ifloslangan qon orqali yuqadi. 📌Gepatit C sabablari 📌Gepatit C virusi gepatit C infeksiyasini keltirib chiqaradi. Virus…

🔶Gepatit B kasalligining sabablari 🔶Kasallik asosan qon orqali yuqadigan gepatit B virusi bilan tanaga zarar yetkazish natijasida yuzaga keladi. 🔶Gepatit B sabablari: 🔶himoyalanmagan jinsiy aloqa, jinsiy sherikning tez-tez o’zgarishi; 🔶inyeksion giyohvand moddalarni iste’mol qilish, tatuirovka salonlari xizmatlaridan foydalanish (iflos igna…

#infografika «Gepatit A (Botkin,sariq kasalligi).» Sanepidqoʻmita Qarshi tuman boʻlimi Axborot xizmati https://t.me/sanepidqom_qarshitum
